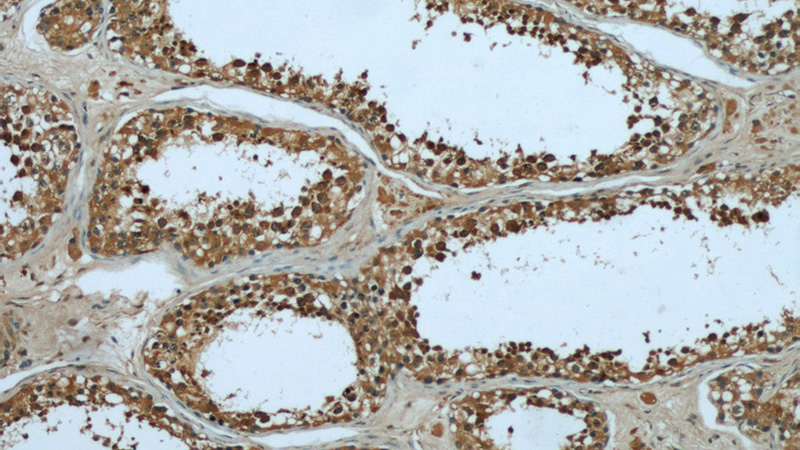
Immunohistochemical of paraffin-embedded human testis using Catalog No:112040(KHSRP antibody) at dilution of 1:50 (under 10x lens)
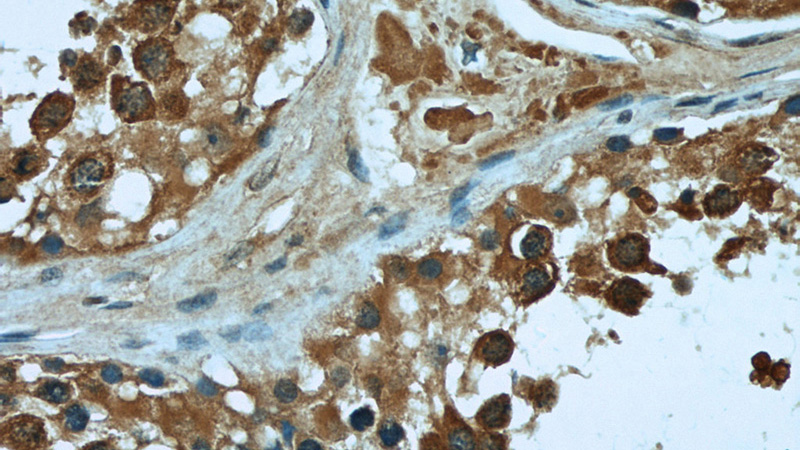
Immunohistochemical of paraffin-embedded human testis using Catalog No:112040(KHSRP antibody) at dilution of 1:50 (under 40x lens)

-
Product Name
KHSRP antibody
- Documents
-
Description
KHSRP Rabbit Polyclonal antibody. Positive IF detected in HeLa cells. Positive IHC detected in human testis tissue. Positive WB detected in HeLa cells, Jurkat cells. Observed molecular weight by Western-blot: 75kd
-
Tested applications
ELISA, WB, IHC, IF
-
Species reactivity
Human,Mouse,Rat; other species not tested.
-
Alternative names
FBP2 antibody; FUBP2 antibody; FUSE binding protein 2 antibody; KHSRP antibody; KSRP antibody; p75 antibody
-
Isotype
Rabbit IgG
-
Preparation
This antibody was obtained by immunization of Peptide (Accession Number: NM_003685). Purification method: Antigen affinity purified.
-
Clonality
Polyclonal
-
Formulation
PBS with 0.02% sodium azide and 50% glycerol pH 7.3.
-
Storage instructions
Store at -20℃. DO NOT ALIQUOT
-
Applications
Recommended Dilution:
WB: 1:200-1:2000
IHC: 1:20-1:200
IF: 1:20-1:200
-
Validations

HeLa cells were subjected to SDS PAGE followed by western blot with Catalog No:112040(KHSRP antibody) at dilution of 1:500
Immunohistochemical of paraffin-embedded human testis using Catalog No:112040(KHSRP antibody) at dilution of 1:50 (under 10x lens)
Immunohistochemical of paraffin-embedded human testis using Catalog No:112040(KHSRP antibody) at dilution of 1:50 (under 40x lens)

Immunofluorescent analysis of HeLa cells using Catalog No:112040(KHSRP Antibody) at dilution of 1:50 and Alexa Fluor 488-congugated AffiniPure Goat Anti-Rabbit IgG(H+L)
-
Background
KHSRP, also named as FUBP2, KSRP and p75, belongs to the KHSRP family. It binds to the dendritic targeting element and may play a role in mRNA trafficking. KHSRP is a part of a ternary complex that binds to the downstream control sequence (DCS) of the pre-mRNA. It mediates exon inclusion in transcripts that are subject to tissue-specific alternative splicing. KHSRP may interact with single-stranded DNA from the far-upstream element (FUSE). May activate gene expression. It is involved in degradation of inherently unstable mRNAs that contain AU-rich elements (AREs) in their 3'-UTR, possibly by recruiting degradation machinery to ARE-containing mRNAs.
-
References
- Chai F, Li HY, Wang W. Subcellular quantitative proteomic analysis reveals host proteins involved in human cytomegalovirus infection. Biochimica et biophysica acta. 1854(8):967-78. 2015.
- Jiang H, Zhang J, Du Y. microRNA-185 modulates low density lipoprotein receptor expression as a key posttranscriptional regulator. Atherosclerosis. 243(2):523-32. 2015.
Related Products / Services
Please note: All products are "FOR RESEARCH USE ONLY AND ARE NOT INTENDED FOR DIAGNOSTIC OR THERAPEUTIC USE"
